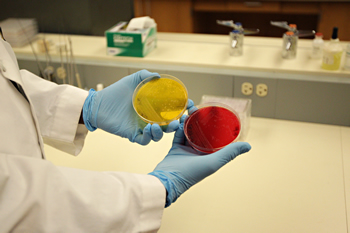

Tuskegee University offers over 60 academic programs to choose from.
Tuskegee University is ranked as the #4 HBCU in the Nation.
Get ready to take flight… because your journey to greatness starts here!
Tuskegee University is the only HBCU to proudly offer ROTC Programs for all of the military branches, including the Space Force!
We have over 100 student organizations on campus, and Championship sports teams for men and women!
The Department of Pathobiology consists of faculty and staff members with expertise in various disciplines, including parasitology, microbiology, virology, anatomic and clinical pathology, public health/epidemiology, immunology, and laboratory animal medicine.
With regards to instruction, our goal is to provide students with high quality teaching in the above disciplines to ensure successful development and assimilation of a strong knowledge base for understanding the pathophysiology and distribution of disease. The following methods are used to accomplish this goal... Read more
![]() |
![]() |
|
Toufic Nashar, DVM, PhD Associate Professor and Department Head Chair of Education Policies Committee (Curriculum) Tuskegee University College of Veterinary Medicine Department of Pathobiology Patterson Building, A403 Tel: Office: 334-727-8366/ Lab. 334-724-4514Fax: 334-724-4110 |
Administrative Administrative Tuskegee University College of Veterinary Medicine Department of Pathobiology Room P129 Phone: 334-727-8511 Fax: 334-724-4110 |
The Department of Pathobiology consists of faculty and staff members with expertise in various disciplines, including parasitology, microbiology, virology, anatomic and clinical pathology, public health/epidemiology, and laboratory animal medicine.
The department has more than thirty faculty and staff members assigned to the various disciplines. The mission of the department is to provide an environment of excellence in teaching, research, and service in the above disciplines for the College of Veterinary Medicine (TUCVM), Tuskegee University, and the local and global community.
In addition, the department’s mission is accomplished through 14 committees which consist of a chairperson and support faculty and staff. These committees have been established to accommodate the standards established by the American Veterinary Medical Association (AVMA). Those standards apply to the School in general and to departments in particular. These 14 committees will report to the department on a regular basis, keeping all members informed and updated on the various AVMA standards and other department functions. The names of the various committees are listed.
Physical Facilities/Equipment
Also, various members of the department are appointed by the Dean to serve in the governance of the School/College in several capacities. They include membership in the TUCVM Academic Advisory Committee, Director of the Diagnostic Laboratories, membership on the College Personnel Committee and University Faculty Senate, appointment of the Attending Veterinarian for the University, and others.

The Department of Pathobiology consists of faculty members with expertise in several disciplines, including microbiology, anatomic and clinical pathology, immunology, parasitology, laboratory animal medicine, epidemiology, and virology.
The Department has more than thirty faculty and staff members on campus assigned to it. The mission of the Department is to provide an environment of excellence in teaching, research, and service in the above disciplines for the College of Veterinary Medicine (TUCVM), Tuskegee University, and the local and global community.
VMED-0800A Introduction to the Veterinary Profession, Animal Welfare and Financial Management
VMED 804A Clinical Skills and Case-Based Learning
VMED-809A-01 Veterinary Immunology
VMED 814 Veterinary Pathology I
VMED 815 Clinical Pathology
VMED 819A Bacteriology, Mycology & Clinical Microbiology-I
VMED 820A Parasitology
VMED 823A Veterinary Endocrinology
VMED 824 Veterinary Pathology II
VMED 825 Veterinary Virology& Clinical Microbiology II
VMED 839A Avian, Exotics & Lab. Animal Diseases
Electives:
PATH 0637 Interp. of Clinical Path Data (Fall & Spring)
PHSI 0445 01 Advanced Endocrinology (Summer, Fall, Spring, 4th Y students only)
VMED 0886 Cetacean Medicine Elective (Fall)
PATH-0637-01 Inter of Clinical Path Data
VMED 0887 Oceanarium Medicine (Spring)
Department of Pathobiology - Faculty / Staff
|
FACULTY |
|
TITLE |
PHONE # |
|
Associate Professor/Department Head |
334.727.8366 |
||
|
Professor/Director Food Animal Health & Food Safety |
334.727.8278 |
||
|
Assistant Professor/Director of Diagnostic Lab Services |
334.727.8553 |
||
|
Alexander, Dr. Deloris |
Professor/Joint Appointment with CAENS |
334.552.0690 |
|
|
Intern: Anatomic Pathology |
334.421.2407 |
||
|
Anderson, Dr. Dennis |
Associate Professor |
334.724.4102 |
|
|
Burke, Dr. Robin |
Professor, Laboratory Animal Medicine/Director of Comparative Medicine Resource Center |
||
|
Assistant Professor/Section Chief of Necropsy |
334.727.8175 |
||
|
Dibaba, Dr. Asseged Bogale |
Associate Professor/Public Health |
334.724.4170 |
|
|
Associate Professor/Section Chief of Clinical Pathology |
334.724.4105 |
||
|
Assistant Professor/Research Specialist |
334.724.4163 |
||
|
Gilbreath, Dr. Ebony |
Professor/Dean |
334.724.4103 |
|
|
Associate Professor, Clinical Pathology |
334.727.8231 |
||
|
Professor//Pathology |
334.724.4273 |
||
|
Clinical Instructor of Pathology |
|
||
|
Assistant Professor/Benjamin-Carver FIRST Scientist |
|
||
|
Associate Professor |
334.727.8729 |
||
|
Clinical Instructor of Anatomic Pathology |
334.421.3352 |
||
| Odemuyiwa, Dr. Solomon | sodemuyiwa@tuskegee.edu | Associate Dean of Preclinical Curriculum, Professor | 334.727.8753 |
|
Platt, Dr. Terrance |
Assistant Director Comparative Medicine (CMRC) |
404.964.1625 |
|
|
Clinical Instructor/Coordinator of Educational Programs |
334.724.4678 |
||
|
Associate Professor |
334.727.8698 |
||
|
Associate Professor/Associate Dean of Res. & Adv. Studies |
334.724.4547 |
||
|
Assistant Professor |
|
||
|
Professor |
334.727.8107 |
||
|
Dr. Gbemisola Akingbade |
Assistant Professor of Anatomic Pathology |
|
|
|
STAFF |
|
|
|
|
Diagnostic Laboratory Manager/Supervisor |
334.724.4282 |
||
|
Medical Technologist/Clinical Pathology |
334.724.4109 |
||
| Babiker, Yousra | ybabiker@tuskegee.edu | ||
|
Baker, Edward |
Necropsy Technician |
334.724.4112 |
|
|
Director of Compliance/Microbiology Technician |
334.727.8726 |
||
|
Histotechnologist |
334.724.4111 |
||
|
Pearsall, Anthony |
Lab Animal Technician, Comparative Medicine |
334.552.1308 |
|
|
Administrative Assistant Comparative Medicine (CMRC) |
334.727.8234 |
||
|
Administrative Assistant/Pathobiology Department Secretary |
334.727.8511 |
||
|
Walker, Leonard |
|
Lab Animal Technician, Comparative Medicine |
|
|
|
|
|
|
|
INTERNS |
|
|
|
|
Almokaddem, Dr. Asmaa |
Intern: Anatomic Pathology |
334.421.2407 |
|
|
Dr. Gajanayaka Mudalige Vidura |
|
Intern: Clinical Pathology |
|
